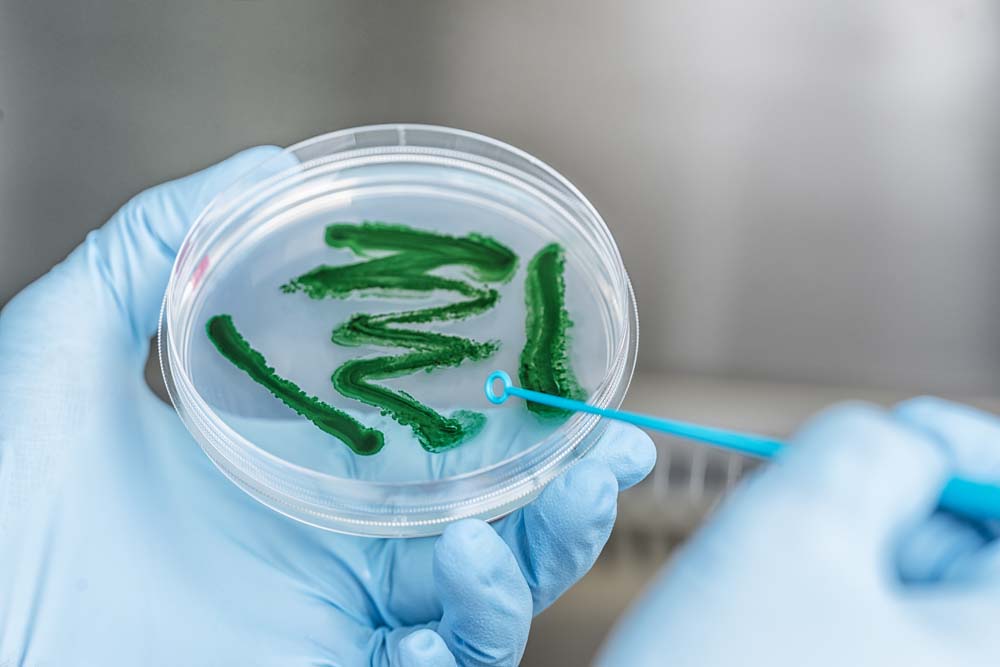

Transfer News
January - March 2021
New standard for reproducible cytometric microbiome analysis
Flow cytometric histogram of a mock community © Susann Müller, UFZ
In flow cytometry alignment beads are valuable, but often not sufficient for validating lab workflows and comparison of data between experiments. The cytometric mock community of the UFZ solves these problems. We applied for a patent and ask you to develop a kit together and bring it to the (clinical) market!
Flow cytometry has recently established itself as a tool to track short-term dynamics in microbial community assembly and link those dynamics with ecological parameters. However, instrumental configurations of commercial cytometers and variability introduced through differential handling of the cells and instruments frequently cause data set variability at the single-cell level. This is especially pronounced with microorganisms, which are in the lower range of optical resolution. Although alignment beads are valuable to generally minimise instrumental noise and align overall machine settings, an artificial microbial cytometric mock community (mCMC) is mandatory for validating lab workflows and enabling comparison of data between experiments, thus representing a necessary reference standard for the reproducible cytometric characterisation of microbial communities, especially in long-term studies. Benchmarked data sets allow the use of bioinformatic evaluation procedures to decode community behaviour or convey qualified cell sorting decisions for subsequent high-resolution sequencing or proteomic routines.
Paper: Bacterial mock communities as standards for reproducible cytometric microbiome analysis, Nicolas Cichocki, Thomas Hübschmann, Florian Schattenberg, Frederiek-Maarten Kerckhof, Jörg Overmann, Susann Müller; Nat Protoc. 2020: 2788-2812. doi: 10.1038/s41596-020-0362-0.
March 2021
Hydrogen from cyanobacteria
Petri dish with cyanobacterial biofilm © Andre Künzelmann, UFZ
Johanna Wiedener, a student at the University of Leipzig, has been awarded the prize of the German Society for Plant Sciences (DBG) for the best master's thesis in plant science. The master's thesis "Investigation of a mixed species cultivation concept for a continuous photosynthesis-driven hydrogen production" was written at the UFZ Department of Solar Materials in the group of PD Dr Stephan Klähn.
Petri dish with cyanobacterial biofilm © Andre Künzelmann, UFZ
Johanna Wiedener, a student at the University of Leipzig, has been awarded the prize of the German Society for Plant Sciences (DBG) for the best master's thesis in plant science. The master's thesis "Investigation of a mixed species cultivation concept for a continuous photosynthesis-driven hydrogen production" was written at the UFZ Department of Solar Materials in the group of PD Dr Stephan Klähn.
In the future, hydrogen will play a central role in our energy supply and thus contribute to the energy transition, as it would make it possible to significantly reduce CO2 emissions with the help of renewable energies, especially in industry and transport.
That’s why, in her work, Johanna Wiedener dealt with the continuous production of hydrogen through photosynthetic microorganisms (cyanobacteria). She addressed the problem that the hydrogenases necessary for hydrogen production obtain electrons from photosynthesis, but are simultaneously inactivated by the oxygen produced during photosynthesis.
Johanna Wiedener has succeeded for the first time in keeping the environment anaerobic by co-cultivation with a heterotrophic bacterium and thus achieving hydrogen synthesis that can be measured over several hours. She was able to prove that it is the cyanobacterial partner that produces this hydrogen and actually uses electrons from photosynthetic water splitting. She was also able to transfer her observations to an alternative, stable cultivation concept: a bacterial biofilm. Here, significant hydrogen synthesis could be documented even after several weeks. Although numerous problems still need to be solved, Johanna Wiedener has taken this biological approach to hydrogen production a significant step towards application.
Award of the German Society for Plant Sciences for the best Master's thesis in plant science
February 2021
UFZ as virtual host of 14th Saxon Transfer Network Meeting
 On 03 February 2021, the 14th meeting of the futureSAX - Saxon Transfer Network took place online at the Helmholtz Centre for Environmental Research GmbH - UFZ. Under the motto "Achieving more together", about 40 participants took the opportunity to exchange their experiences on professionalising transfer processes and to find out about transfer and cooperation formats of the Federal Agency for Disruptive Innovations (SPRIND) and the Automotive Cluster East Germany (ACOD).
On 03 February 2021, the 14th meeting of the futureSAX - Saxon Transfer Network took place online at the Helmholtz Centre for Environmental Research GmbH - UFZ. Under the motto "Achieving more together", about 40 participants took the opportunity to exchange their experiences on professionalising transfer processes and to find out about transfer and cooperation formats of the Federal Agency for Disruptive Innovations (SPRIND) and the Automotive Cluster East Germany (ACOD).
In his keynote speech, Dr Joachim Nöller, Head of the Knowledge and Technology Transfer Department at the UFZ, explained the organisational progress that has been made in technology transfer at the UFZ in recent years and addressed topics such as the establishment of efficient processes, the development of a transfer project pipeline with targeted measures for the further development of prioritised transfer projects, the strengthening of technology marketing and how to professionalise the transfer unit itself.
"In our transfer strategy, we focus on dialogue with the actors and thus on the joint development of solutions that are oriented towards prevention. We must continue to promote this essential dialogue between research and industry, because it also creates the important basis of trust between the partners for innovation projects," Joachim Nöller emphasised once again at the end in the discussion round of all speakers.
In addition, Joachim Nöller gave further insights into transfer at the UFZ in a futureSAX transfer interview conducted in advance.
Would you like to know more about our technologies and processes? Then please contact us!
Click here for the presentations!
The Saxon Transfer Network brings together around 80 institutions (research institutions, universities, chambers, business development agencies) from all over Saxony and facilitates the personal exchange of experiences between transfer actors on the subject of knowledge and technology transfer. To this end, network meetings on transfer-relevant topics take place every six months at the Saxon Transfer Network partners.
February 2021
HTWK Leipzig and UFZ to expand cooporation
 The UFZ and the Leipzig University of Applied Sciences (HTWK Leipzig), together with HTWK’s Research and Transfer Centre (FTZ), have signed a framework agreement to expand their cooperation at the Leipzig science location. The cooperation agreement will further strengthen scientific expertise at the science location Leipzig.
The UFZ and the Leipzig University of Applied Sciences (HTWK Leipzig), together with HTWK’s Research and Transfer Centre (FTZ), have signed a framework agreement to expand their cooperation at the Leipzig science location. The cooperation agreement will further strengthen scientific expertise at the science location Leipzig.
The contract and the specific agreements on joint property rights and the use of scientific infrastructure are intended to further consolidate the long-standing and trusting cooperation and to expand synergies. On the one hand, this concerns very successful projects such as the joint development of environmental technology processes using radio waves, from which numerous cooperation projects, an innovation network of companies and research institutions (RWTEC) and a technology-oriented spin-off (RWInnoTEC) have emerged. On the other hand, the agreement also initiates new joint research projects on the energy transition, structural change or the city of the future. Among other things, a platform for innovation and technology transfer will be developed which focuses on the environment and sustainability with close links to the Saxony5 transfer network, an association of universities of applied research in Saxony.
The cooperation agreement expands the existing cooperation between the institutions and forms the framework for new formats and strategies. This will intensify the exchange and expand contacts in business, science and society. Experimental and theoretical work and the exchange of personnel between the two institutions will be facilitated by allowing researchers to use the laboratories, workshops, libraries or services of the cooperating institutions. Further synergies will be created with joint professorships, the qualification of young scientists or joint events to strengthen the transfer of information and knowledge, especially to the region. The two partners see it as particularly important to conduct even more joint research with industry and society in the future.
February 2021
Prof. Dr. Daniela Thrän elected Co-Chair of the Bioeconomy Council
 Prof. Daniela Thrän, © UFZ
The Bioeconomy Council, which was newly appointed by the German government in December 2020, transferred the chair of the advisory council to two female scientists: Prof. Dr. Daniela Thrän, a systems scientist at the UFZ and the German Biomass Research Centre (DBFZ), and Prof. Dr. Iris Lewandowski, a bioenergy expert at the University of Hohenheim. The two female scientists to serve on its chair for the next three years.
Prof. Daniela Thrän, © UFZ
The Bioeconomy Council, which was newly appointed by the German government in December 2020, transferred the chair of the advisory council to two female scientists: Prof. Dr. Daniela Thrän, a systems scientist at the UFZ and the German Biomass Research Centre (DBFZ), and Prof. Dr. Iris Lewandowski, a bioenergy expert at the University of Hohenheim. The two female scientists to serve on its chair for the next three years.
"The bioeconomy is a fundamental building block of our future economic system. It is important to me to quickly and fully exploit the many and varied opportunities and innovation potential of bioeconomy, as they are urgently needed for sustainable development both in Germany and in the international arena," says Daniela Thrän. "The new Bioeconomy Council combines a unique body of expertise to support this transformation based on knowledge."
About the person
Prof. Dr. Daniela Thrän is an environmental protection engineer. As a systems scientist, she conducts research on the effects of the sustainable use of renewable resources for energy and materials. She has headed the UFZ Department of Bioenergy since 2011 and is also the head of the "Bioenergy Systems" department at the German Biomass Research Centre (DBFZ) in Leipzig. She is also a spokesperson for the UFZ's integrated platform for sustainability transition. She chairs the Bioenergy Systems department at the University of Leipzig. Daniela Thrän is a member of numerous advisory councils on the German federal and state level.
About the Bioeconomy Council
The Federal Ministry of Education and Research (BMBF) and the Federal Ministry of Food and Agriculture (BMEL) first established a Bioeconomy Council as an advisory body to the German government in 2009. Its tasks included providing important input for the "National Research Strategy Bioeconomy 2030" and the "National Policy Strategy Bioeconomy". The German federal government adopted the National Bioeconomy strategy, bundling government bioeconomy policy activities, in January of 2009. The third Bioeconomy Council was appointed In December 2020 and consists of 20 experts from the areas of science, business and society. As an independent and neutral body, the Bioeconomy Council has the task of advising the German federal government on the implementation of the strategy with recommendations and position statements while simultaneously promoting public debate on the bioeconomy.
Source: Press and Public Relations
January 2021
Prof. Dr. Katja Bühler appointed to the German National Hydrogen Council
 Model graphic: predicting protonophoric uncoupling activity, © Verlag ACS Publications
The German Federal Cabinet appointed Prof. Dr. Katja Bühler to the National Hydrogen Council (NWR). This council of experts has the task of advising the Federal Government with proposals and recommendations for action in the implementation and further development of the National Hydrogen Strategy adopted in 2020.
Model graphic: predicting protonophoric uncoupling activity, © Verlag ACS Publications
The German Federal Cabinet appointed Prof. Dr. Katja Bühler to the National Hydrogen Council (NWR). This council of experts has the task of advising the Federal Government with proposals and recommendations for action in the implementation and further development of the National Hydrogen Strategy adopted in 2020.
With the National Hydrogen Strategy, the German government intends to transform Germany into the lead market and leading provider for green hydrogen technologies in a future climate-neutral economy. The microbiologist Prof. Dr. Katja Bühler and her team are developing options for producing hydrogen with bacteria that are capable of photosynthesis.
"We want to produce biohydrogen efficiently and in a way that is both environmentally and resource-friendly. However, the transition from fundamental research to an industrial application can only be achieved in an integrated, interdisciplinary approach. We are therefore working together with many partners from science and industry to realize this challenging idea. Being appointed to the National Hydrogen Council is a great honour and I will do my best to implement the biotechnological approach into the hydrogen debate" says Katja Bühler.
About the person
Prof. Dr. Katja Bühler is conducting research at the UFZ Department of Solar Materials, which is developing biological alternatives for hydrogen production based on photosynthetically active microbes. This so-called white hydrogen could supplement the current production of green hydrogen, which is produced by electrolysis based on solar or wind energy. Her work focuses on the use of surface-adhered organisms as an alternative solution for continuous bioprocesses.
Video portrait of Prof. Katja Bühler
About the National Hydrogen Council
The National Hydrogen Council was established by the German Federal Government with the decision on the National Hydrogen Strategy on June 10, 2020. The council has the task of advising and supporting the Federal Government with proposals and recommendations for action in the implementation and further development of the hydrogen strategy. The National Hydrogen Council comprises 26 experts from the scientific and industrial communities and from civil society.
Source: Press and Public Relations
January 2021
Predicting mitochondrial dysfunction
 Model graphic: predicting protonophoric uncoupling activity, © Verlag ACS Publications
UFZ scientists have developed a biophysical model to predict pH-dependent uncoupling toxicity of organic acids from their chemical structure. This makes it a convenient predictive model to gain valuable information on the toxicity of organic chemicals already at an early stage of development.
Model graphic: predicting protonophoric uncoupling activity, © Verlag ACS Publications
UFZ scientists have developed a biophysical model to predict pH-dependent uncoupling toxicity of organic acids from their chemical structure. This makes it a convenient predictive model to gain valuable information on the toxicity of organic chemicals already at an early stage of development.
Mitochondrial dysfunction has been implicated as an important factor in the development of idiosyncratic organ toxicity and is caused by protonophoric uncoupling activities of chemical compounds. An ability to predict mitochondrial dysfunction early in the drug development process enables the deselection of those drug candidates with potential safety liabilities, allowing resources to be focused on those compounds with the highest chance of success to the market.
The presented model was tested against literature data measured in chromatophores, submitochondrial particles, isolated mitochondria, and intact green algae cells with good success. All required input information can be derived from the chemical structure. It was also possible to reproduce pH-dependencies in isolated mitochondria and intact cells. Besides the prediction of the ECw, the mechanistic nature of the model allows researchers to draw direct conclusions on the impact of single input factors such as pH- and voltage-gradients across the membrane, the anionic and neutral membrane permeability, and the heterodimerization constant. These insights are of importance in drug design or chemical regulation.More information:
Andrea Ebert and Kai-Uwe Goss, Predicting Uncoupling Toxicity of Organic Acids Based on Their Molecular Structure Using a Biophysical Model, Chem. Res. Toxicol. 2020, 33, 7, 1835–1844
BIOVIA Blog: Predicting Uncoupling Toxicity of Organic Acids
January 2021
Fast identification of neurotoxic effects
 Zebrafish embryo, © UFZ
Optimization of the spontaneous tail coiling test for fast assessment of neurotoxic effects in the zebrafish embryo
Zebrafish embryo, © UFZ
Optimization of the spontaneous tail coiling test for fast assessment of neurotoxic effects in the zebrafish embryo
For a fast evaluation of environmental samples and pure substances, UFZ-scientists optimized the measurement of a behavioural endpoint in zebrafish embryos - the spontaneous tail coiling.
Neuroactive chemicals are frequently detected in the environment. At sufficiently high concentrations or within mixtures, they could provoke neurotoxic effects and neurological diseases to organisms and humans. Fast identification of such neuroactive compounds in the environment could help in hazard assessment and risk mitigation. Behaviour change is considered as an important endpoint and might be directly or indirectly connected to a neuroactive mode of action. The here described optimized test of the spontaneous tail coiling assessment together with the automated analysis in KNIME(R) indicate opportunities for the harmonization of the test and further development for prospective and diagnostic testing.
Paper:
Ogungbemi, Afolarin; Teixido, Elisabet; Massei, Riccardo; Scholz, Stefan; Kuester, Eberhard; NEUROTOXICOLOGY AND TERATOLOGY, Volume: 81, DOI: 10.1016/j.ntt.2020.106918
January 2021
